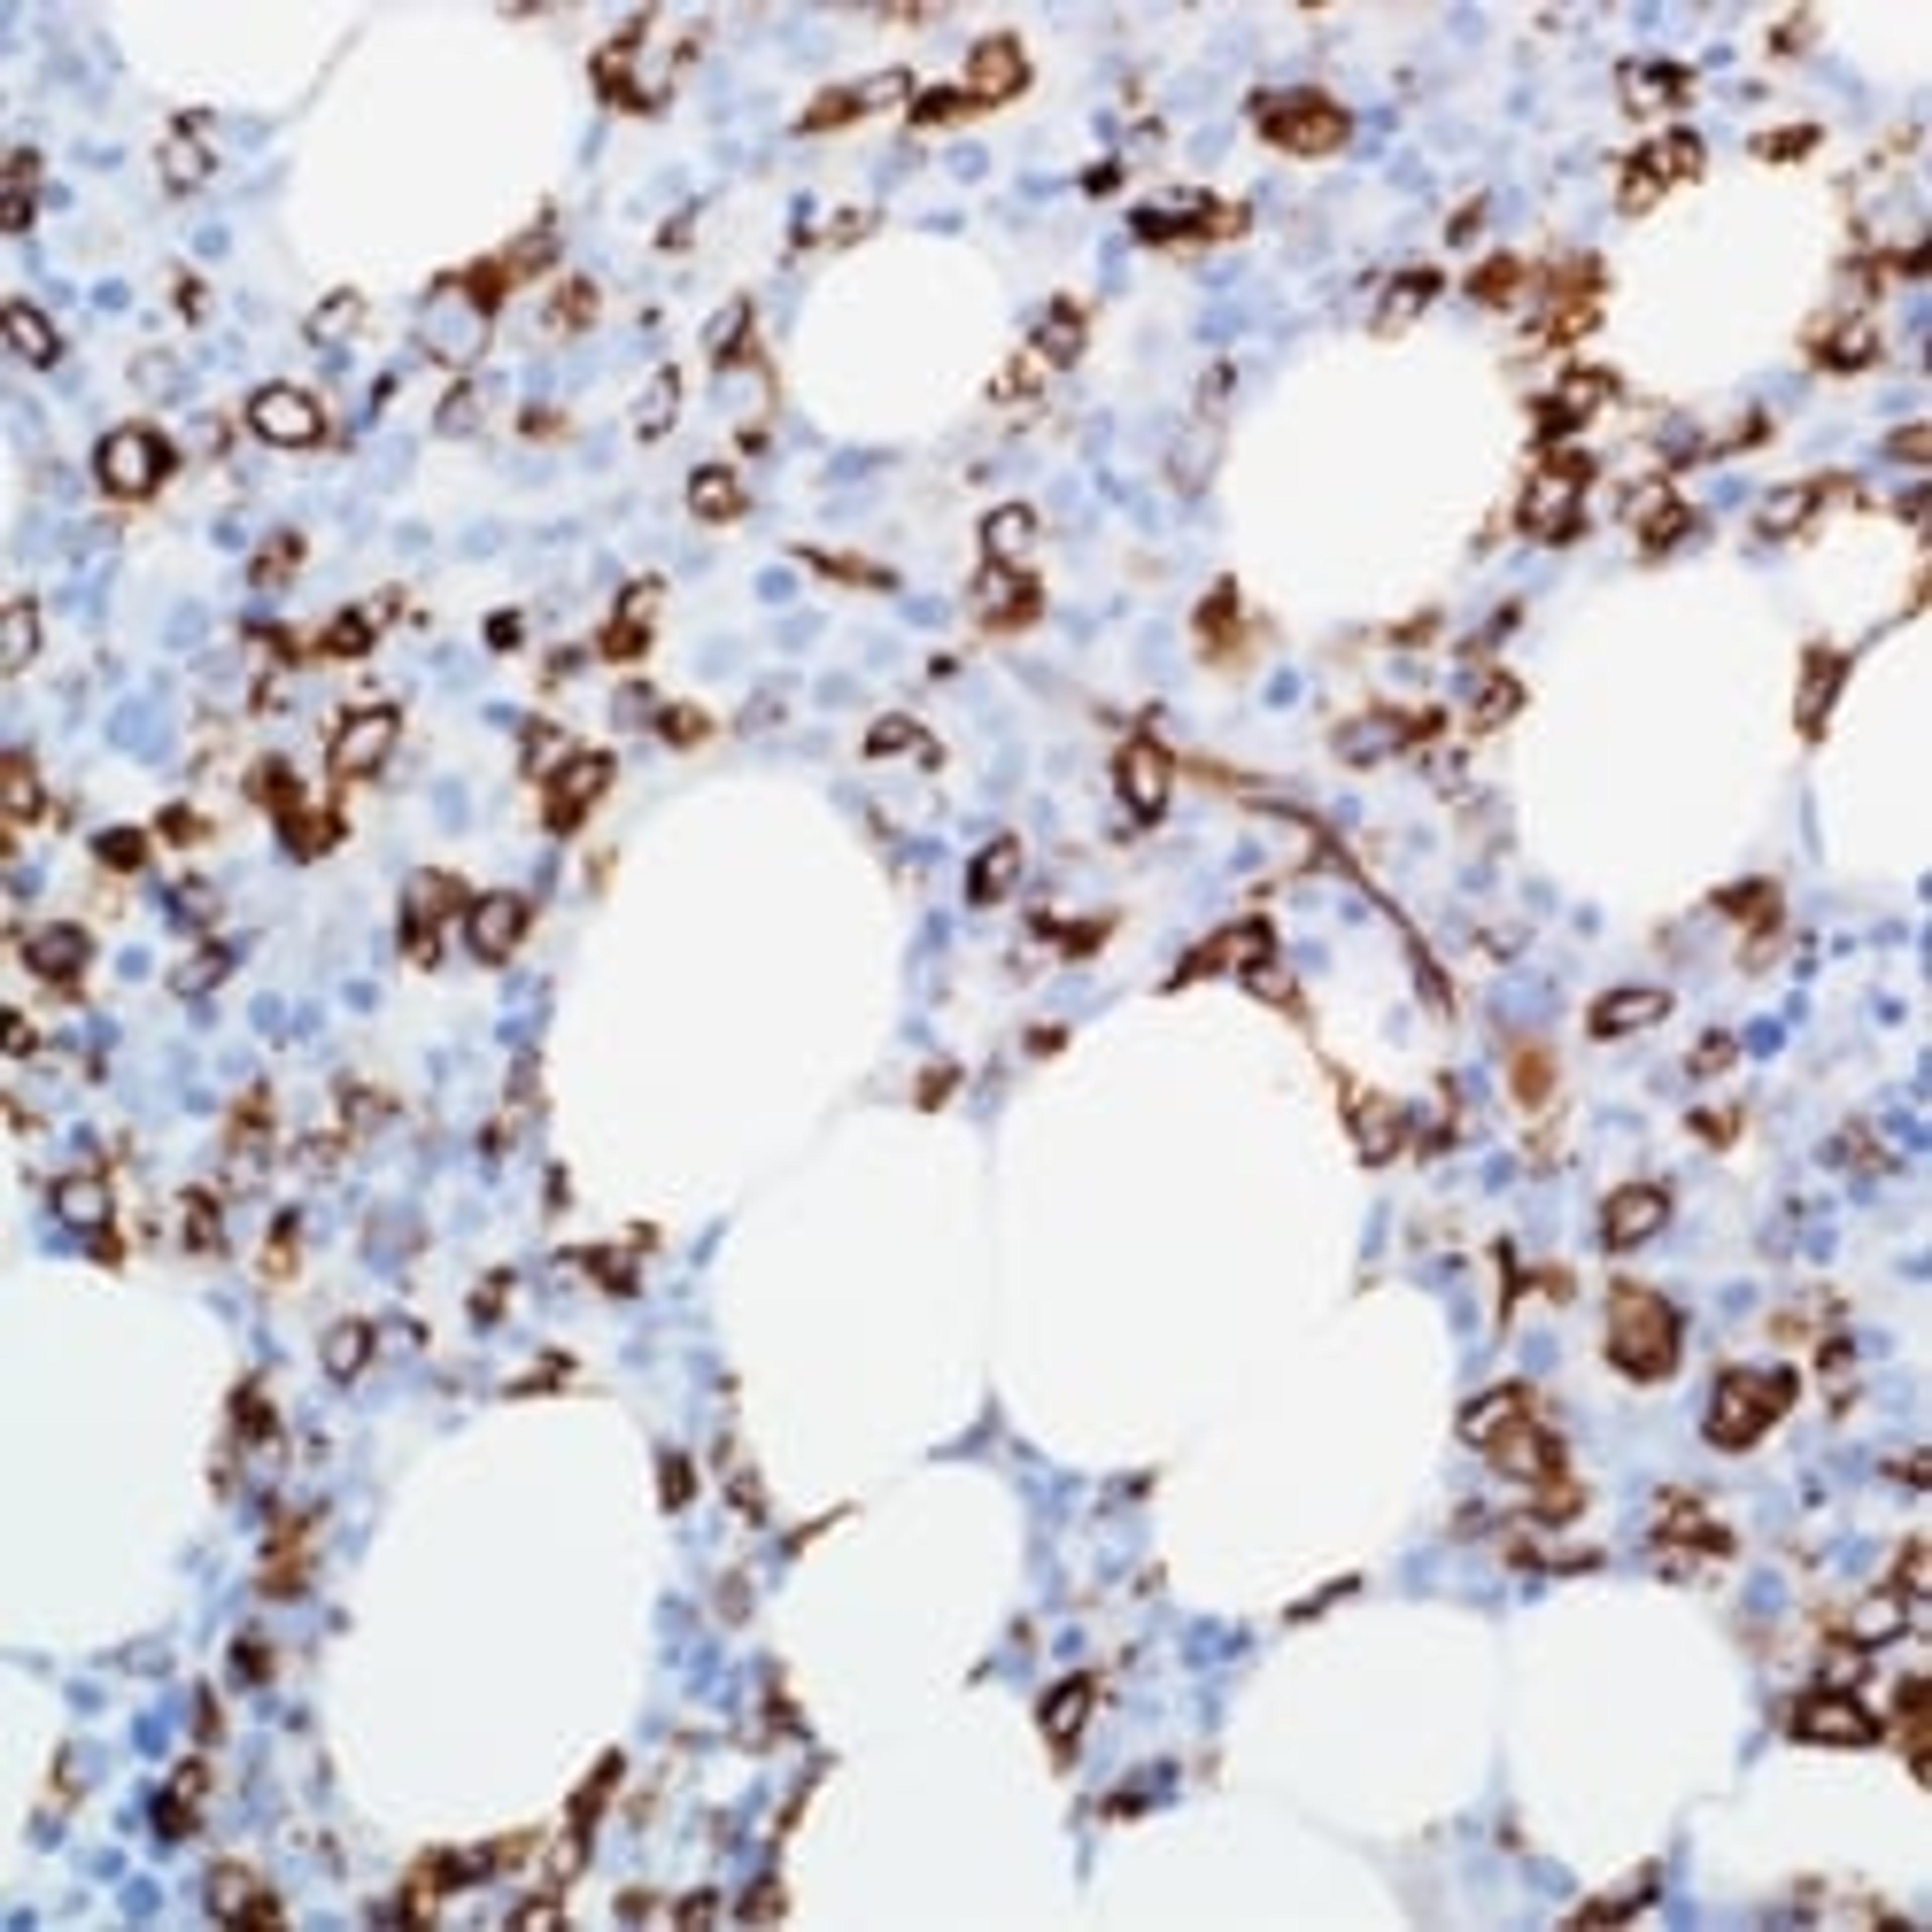

Life Sciences
CD34 (QBEnd/10)
Merck
By completing this form, you will receive a free membership to SelectScience and The Scientists' Channel. SelectScience is a trade organisation, we do not provide services to consumers and membership is for business purposes only. As a member you must provide us with a corporate email address to enable us (and our advertisers and sponsors) to contact you for marketing purposes. You can opt-out of marketing at any time. See our Privacy Policy.
As a subscriber of SelectScience, I can access up-to-date info all in one place - for free!
Wolfgang Muss Salzburg General Hospital